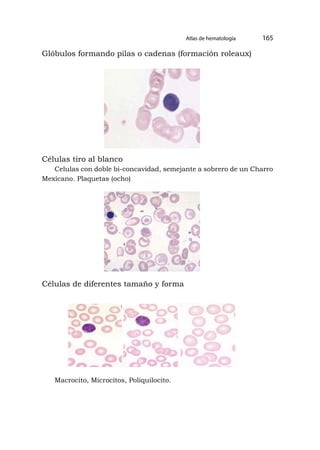
Glóbulos formando pilas o cadenas (formación roleaux)
Células tiro al blanco
Celulas con doble bi-concavidad, semejante a sobrero de un Charro
Mexicano. Plaquetas (ocho)
Células de diferentes tamaño y forma
Macrocito, Microcitos, Poliquilocito.
Atlas de hematología 165

Este documento presenta las normas de bioseguridad que deben seguirse en el laboratorio clínico. Describe las normas generales como el uso de batas, guantes y señalización adecuada. También cubre el manejo y disposición segura de desechos biológicos. El objetivo principal es proteger la salud de los estudiantes y personal a través de medidas universales durante la manipulación de muestras biológicas.












![[13]
Prólogo
El análisis clínico representa un apoyo primordial para el área médica,
ya que a través de los fluidos corporales como sangre, orina, líquido
seminal, líquido cefalorraquídeo, etc., se pueden diagnosticar diferentes
patologías y establecer el tipo de tratamiento que se debe administrar
al paciente. Conscientes de la gran importancia y con la finalidad de
alcanzar un trabajo de calidad, es indispensable contar con un texo
guía de Análisis Clínico I que presente de manera formal y sistemática
desarrollos experimentales en el área de laboratorio de análisis clínico,
especialmente en esta primera de Hematología, Coagulación sanguínea
y Bioquímica Clínica.
Es por ello que se ha elaborado de forma sencilla y práctica para
que su contenido sea de fácil aplicación para los estudiantes de la
Unidad Académica de Ciencias Químicas y de la Salud de la Universidad
Técnica de Machala, en la cual se desarrollan estas actividades
diarias. Esta guía es el resultado de gran esfuerzo y dedicación para
los estudiantes de quinto año de la Unidad Académica de Ciencias
Químicas y de la Salud de la Universidad Técnica de Machala, ubicada
en la Panamericana Kilometro 5 1/2 Vía a Pasaje, la misma que será de
gran utilidad en el Laboratorio de Microbiología y Bioquímica.
El análisis clínico es un campo multidisciplinario cuya finalidad es
la aplicación de la Ciencia Química para contribuir a la resolución de
problemas de salud. La función de las materias de aplicación de Análisis
Clínico es realizar análisis, tanto cualitativos como cuantitativos,
en fluidos corporales como sangre, orina, líquido seminal, líquido
cefalorraquídeo, etc. Para que los resultados de dichos análisis sean
útiles a los médicos en el diagnóstico, tratamiento y seguimiento de](https://image.slidesharecdn.com/11analisisclinicoi-230422212652-fbea794d/85/11-ANALISIS-CLINICO-I-pdf-13-320.jpg)

![[15]
Introducción
Los desarrollos experimentales de Análisis Clínicos se ocupan de realizar
estudios microbiológicos, químicos, inmunológicos y hematológicos de
productos, excreciones secreciones, del hombre, para establecer un
mejor diagnóstico y facilitar el tratamiento de las enfermedades.
Estos procesos prácticos de Análisis clínico I son fundamentales, ya
que se realizan las mediciones y reportes de los componentes químicos
disueltos en la sangre, utilizando el suero de la misma ya que está libre
de células y específicamente donde se encuentran los componentes
disueltos, en la cual se analizan diversas cantidades de elementos,
según sea requerido por el médico o el propio paciente.
Los estudios de laboratorio forman parte del proceso de atención a
la salud el cual se apoya en el estudio de distintas muestras biológicas
mediante su análisis y que brinda un resultado objetivo que puede ser
tanto cuantitativo (un número, como en el caso de la cifra de glucosa)
o cualitativo (positivo o negativo).
Los nuevos métodos analíticos se desarrollan con el fin de mejorar
la exactitud y la precisión de los métodos existentes, también tiene el
propósito de permitir el manejo de equipo automatizado, para reducir
los costos de los reactivos o de la mano de obra, o para medir un
compuesto nuevo. En cualquier caso, se debe verificar experimental-
mente el rendimiento analítico en el laboratorio clínico. La extensión
de los experimentos y la interpretación de los datos van a depender del
propósito de la evaluación y de quien la realiza, pero el fundamento
básico y el diseño experimental son similares en todas las evaluaciones.
Los laboratorios usan diferentes valores de referencia o normales
para los resultados de cada prueba es decir cada uno establece los](https://image.slidesharecdn.com/11analisisclinicoi-230422212652-fbea794d/85/11-ANALISIS-CLINICO-I-pdf-15-320.jpg)

![[17]
Bioseguridad y usos de la sangre
Normas de Bioseguridad en el laboratorio
Introducción
Bioseguridad se refiere a la calidad de ser seguro, libre de riesgo o
peligro. La bioseguridad se define como un conjunto de medidas
encaminadas a proteger a los trabajadores y los pacientes de la
exposición a riesgos biológicos en el laboratorio, así como también la
protección del ambiente. Compromete también a todas aquellas otras
personas que se encuentran en la institución. Pese a considerarse un
tema novedoso, lo que ha ocurrido es un cambio en la visión en torno
a este tema y que ha llevado a preocuparse y buscar metodologías de
implementación en los laboratorios. Es legítimo pensar que el concepto
de bioseguridad da cabida a la protección contra otros elementos que no
son estrictamente de origen biológico pero que son capaces de constituir
riesgo y agresión, por este motivo, deben considerarse medidas de
protección al manipular sustancias como: tóxicos, energizantes,
cancerígenos, hormonas, antibióticos, entre otros. Algunos de los
pilares fundamentales de la bioseguridad que deben considerarse en la
aplicación de los procedimientos asociados a este tema son:
• Universalidad
Las medidas de bioseguridad son aplicables a todo el personal del
laboratorio y durante todos los procesos que en él se desarrollan.
• Uso de barreras
Permite evitar la exposición directa a los fluidos biológicos o
sustancias químicas peligrosas.](https://image.slidesharecdn.com/11analisisclinicoi-230422212652-fbea794d/85/11-ANALISIS-CLINICO-I-pdf-17-320.jpg)

























![SERIE ROJA CONCEPTO
VALORES
COMENTARIOS
HOMBRE MUJER
Encarg.,dos del
4.5- 6.5 3.8 - 5.8
Er itro<:it:os transporte de O>. m1ll./ mml m1ll./ mml
Proteínaen la que - Para el trtetlon debemos
Hemoglobina
se produce la l'I - 18 12 -16 buscar valoresaltos.
fijaoon de 02 para g/ di g 1 di - Menosde 12 g /di:
su transporte poslble a nemla.
o/o de eritrocitos en - Los triatletas pueden
Hematocrlto
el volumen total de
40 - 50 '*' 35-<!5% tener valores bajos por el
sangre incremento del vol
umen
sancuineo.
Volumen Volumen, tamaño de
corpuscular los hematíe-s.. 80 -98 fL
medio - En anertuas por falte de
Hemoglobina cantidad media de hierro el VCMes bajo.
corpuscular Hb por hemane 27- 32 pgr
media - SI VCM aumenta, la HCM
Concentración Concentraclón de Hb también aumenta. CHCM
deHb por hematíesegún 30-389 /di
permanece normal.
corpuscular su volumen.
media = Hb I Hematocrlto.
[43]
Citometría sanguínea
(Hemograma. Biometria sanguínea) Parámetros prosupuestos
Estudio diferencia de leucocitos
Nombre Porcentaje Vn Absoluta
Meta mielocitos 0 -2 % 0 - 240
Neutrófilos en banda 0 – 6 % 0 – 720
Neutrófilos seg. 55- 75% 2.450 – 9.000
Eusinòfilos 0 – 6 % 0 – 720
Basófilos 0 -2 % 0 – 120
Hematología](https://image.slidesharecdn.com/11analisisclinicoi-230422212652-fbea794d/85/11-ANALISIS-CLINICO-I-pdf-43-320.jpg)







































![[83]
Hemostasia y coagulación
Principales parámetros de hemostasia y coagulación
Valores normales
1. Tiempo de sangría o hemorragia
Valor Normal: 1 – 4 minutos
2. Tiempo de coagulación
Valor Normal: 4 – 8 minutos
3. Tiempo de protrombina
Valor Normal: 11- 14 segundos
4. Tiempo parcial de tromboplastina
Valor Normal: 25- 40 segundos
5. Dosificación del fibrinógeno
Valor Normal: 200- 400 mg/dL
6. Recuento de plaquetas en cámara de neubauer
Valor Normal: 140.000 – 500.000/mm3
7. Retracción del coágulo
Retracción: Parcial a las 2 horas
Consistencia: Firme](https://image.slidesharecdn.com/11analisisclinicoi-230422212652-fbea794d/85/11-ANALISIS-CLINICO-I-pdf-83-320.jpg)













![[97]
Pruebas especiales
Recuento de reticulocitos
Introducción
El recuento de reticulocitos es un parámetro de gran valor en el estudio
de la anemia, ya que permite diferenciar entre los mecanismos central
y periférico. Los reticulocitos son glóbulos rojos inmaduros. Se fabrican
en la médula ósea (el material esponjoso contenido en el interior de
los huesos), desde donde se liberan al torrente sanguíneo, por donde
circulan durante aproximadamente 1 a 2 días antes de acabarse de
transformar en glóbulos rojos maduros. Como norma general, solo
un 1% de los glóbulos rojos presentes en el torrente sanguíneo son
reticulocitos.
Elvalordelrecuentodereticulocitospuedeexpresarseenporcentajes
con respecto a la cifra global de eritrocitos o en valor absoluto.
Esta prueba mide la cantidad de reticulocitos presentes en el
torrente sanguíneo, lo que permite hacernos una idea de la velocidad
con que se fabrican los reticulocitos en la médula ósea.
Objetivo: Que el estudiante desarrolle la habilidad de reconocer
en un frotis apropiadamente teñido los reticulocitos y que realice el
contaje respectivo.
Fundamento:Se basa en el recuento de los Reticulocitos sobre un
extendido de sangre convenientemente coloreado.](https://image.slidesharecdn.com/11analisisclinicoi-230422212652-fbea794d/85/11-ANALISIS-CLINICO-I-pdf-97-320.jpg)













![[111]
Bioquímica sanguínea
Técnica colorimétrica de la glucosa
Introducción
La glucosa es el principal tipo de azúcar que contiene la sangre.
Procede de los alimentos que ingerimos y es la principal fuente de
energía necesaria para desempeñar las distintas funciones de nuestro
cuerpo. Se almacena principalmente en el hígado, el cual tiene un papel
primordial en el mantenimiento de los niveles de éste azúcar en sangre.
Cuando la concentración de glucosa en sangre es demasiado alta
o demasiado baja, puede haber problemas. La principal causa de
una concentración excesivamente elevada de glucosa en sangre es
la diabetes. Por esto es de suma importancia realizarse un examen
sanguíneo por lo menos anualmente, y cuando existe sospecha de
un problema en la sangre se debe realizar este examen con mayor
frecuencia, incluso cada tres meses.
Objetivo: Determinación de la glucosa por el método colorimétrico
Fundamento: En la reacción de Trinder, la glucosa es oxidada a
D-gluconato por la glucosa oxidasa (god), con formación de peróxido
de hidrógeno. En presencia de peroxidasa (pod), el fenol y la 4- ami-
noantipirina (4-AA) se condensan por acción del peróxido de hidrógeno,
formando una quinonaimina roja proporcional a la concentración de
glucosa en la muestra.](https://image.slidesharecdn.com/11analisisclinicoi-230422212652-fbea794d/85/11-ANALISIS-CLINICO-I-pdf-111-320.jpg)



















































![[163]
Glóbulos rojos normales
Disco Bicóncavo, con un halo central pálido.
Plaqueta (una)
Glóbulos rojos con el centro alargado
Célula de forma redonda con halo alargado como boca de pescado.
Atlas de hematología](https://image.slidesharecdn.com/11analisisclinicoi-230422212652-fbea794d/85/11-ANALISIS-CLINICO-I-pdf-163-320.jpg)

![[171]
Anexos
Preparación de reactivos para hematología
A.-Serie roja
Líquido de dilución de eritrocitos (gower)
• Sulfato de Sodio Cristalizado 62.5g
• Ácido acético glacial 167 mL
• Agua destilada c.s.p. 1.000ml
B.-Serie blanca
Reactivo de leucocitos: turk
• Ácido acético glacial 30 ml
• Agua destilada c.s.p. 1.000 ml
• Agregar 4 – 6 gotas de Violeta Genciana al 1%
C.- Serie de trombocítica
Reactivo: líquido de dilución de rees-ecker
• Azul brillante de Cresilo 0.1g
• Citrato de sodio 3.0g
• Formol neutro al 40% 0.2mL
• Agua destilada c.s.p. 100 mL
Refrigerar el reactivo y filtrar antes de usar.](https://image.slidesharecdn.com/11analisisclinicoi-230422212652-fbea794d/85/11-ANALISIS-CLINICO-I-pdf-171-320.jpg)



![[175]
A
Absorbancia.- La absorbancia, A, es la cantidad de intensidad de
luz que absorbe la muestra.
Ácido pícrico.- El Trinitrofenol (tnp), también denominado ácido
pícrico, de fórmula química C6H2OH (NO2)3, es un explosivo que
se utiliza como carga aumentadora para hacer explotar algún otro
explosivo menos sensible como el tnt.
Ácido úrico.- Es un producto de desecho del metabolismo de
nitrógeno en el cuerpo humano (el producto de desecho principal es la
urea), y se encuentra en la orina en pequeñas cantidades.
Anemia - trastorno de la sangre causada por una deficiencia de
glóbulos rojos o de hemoglobina (proteína presente en los glóbulos
rojos cuya función principal es el transporte de oxígeno).
Anemia aplásica - tipo de anemia que se desarrolla cuando la
médula ósea produce muy poca cantidad de los tres tipos de células de
la sangre: glóbulos rojos, glóbulos blancos y plaquetas.
Anemia drepanocítica - de hemoglobina C - trastorno de la sangre
en el cual se encuentra una copia del gen que causa la anemia
drepanocítica (HbS) y una copia de otro gen de hemoglobina alterado
(HbC). Este trastorno es similar a la anemia drepanocítica.
Anemia drepanocítica - de hemoglobina E - trastorno de la sangre
en el cual se encuentra una copia del gen que causa la anemia
drepanocítica (HbS) y una copia de otro gen de hemoglobina alterado
(HbE).
Anemia drepanocítica o de células falciformes - trastorno hereditario
de la sangre caracterizado por hemoglobina anormal, en la cual están
Glosario](https://image.slidesharecdn.com/11analisisclinicoi-230422212652-fbea794d/85/11-ANALISIS-CLINICO-I-pdf-175-320.jpg)







![[183]
Textos
Beutler, Ernest, et all (2005) “Williams Hematologia Tomo I-II”. Editorial
Marban libros. SI Madrid España
Cotran RS, Kumar V, Collins (2000) “patología estructural Y funcional”.
Editorial McGraw-Hill-Interamericana 6° Edición México.
Garcia Espinoza, Benjamin et all. (2001). “Hematología tomo I y II 2da
Edición. Editorial Paraninfo Madrid-España.
Grignaschi, Victor. (2003). “Diagnóstico citológico de las Hemopatías”.
Editorial Panamericana México.
Mazza, Joseph. (2004). “Hematología Clínica”. Editorial Marban Madrid
España.
Nagel, R. (2003). “Methemoglobinemias and unstable hemoglobins”. In:
Goldman L, Ausiello D, eds. Cecil Medicine. 23rd ed. Philadelphia.
O´ Connor, Barbara. (1993).”A color atlas and instruction manual of
peripheral blood cell morphology. Editorial Williams & Wilkins
Baltimore USA.
Carr, Jacqueline. Rodak, Bernadette. Atlas de Hematología Clínica.
3era Edición .Editorial Medica Panamericana 2010.
Pagana pagana, Guía de pruebas diagnósticas y de laboratorio-11va
Edición Editorial Mosby/Doyma libro
Powers, Laurence (1989). “Diagnostic Hematology”. Editorial Mosby
Company Missouri USA.
Ruiz Argulles, G. J. (2004). “Fundamentos de Hematología.” 3era
Edición. Editorial Panamericana. México.
Seiverd, Chales (1992).”Hematology for Medical Technologist 5ta
Biliográfia](https://image.slidesharecdn.com/11analisisclinicoi-230422212652-fbea794d/85/11-ANALISIS-CLINICO-I-pdf-183-320.jpg)

![[185]
Núñez Quezada Thayana
Nació en la ciudad de Quito , Provincia de Pichincha el 04 de Marzo
de 1969, Magister en Gerencia en Salud para el Desarrollo Local,
Especialista en Gerencia y Planificación Estratégica de Salud,
Diplomado Superior de Cuarto Nivel en Desarrollo Local y Salud -
Universidad Particular de Loja (Ecuador). Doctora en Bioquímica y
Farmacia – Universidad Técnica de Machala (Ecuador). Docente de
la Universidad Técnica de Machala Unidad Académica de Ciencias
Químicas y de la Salud – Carrera de Bioquímica y Farmacia imparte
la Asignatura de analisis clinico I y analisis clinico II desde el año
2010 hasta la actualidad.Fue Coordinadora de la Carrera de Ciencias
Médicas (2013-2015) de la utmach, Actualmente Coordinadora de la
Carrera de Bioquímica y Farmacia.
Emerson Armando Maldonado Guerrero
Nació en la ciudad de Machala, Provincia de El Oro el 05 de Mayo de
1979, Egresado de la Maestría en Ingeniería Ambiental y Seguridad
Industrial – Universidad Nacional de Piura; Bioquímico Farmacéutico
– Universidad Técnica de Machala. Docente de la Unidad Académica de
Ciencias Químicas y de la Salud – Carrera de Ciencias Médicas de la
Universidad Técnica de Machala. Consultor, Asesor y Capacitador en el
Área de Seguridad y Salud Ocupacional.
Biografía](https://image.slidesharecdn.com/11analisisclinicoi-230422212652-fbea794d/85/11-ANALISIS-CLINICO-I-pdf-185-320.jpg)


